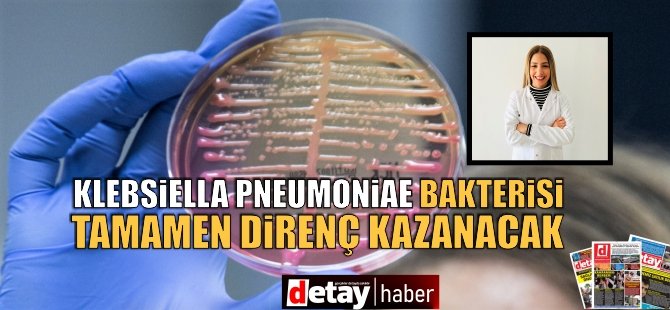

“Klebsiella pneumoniae” bakterisi 5 yıl sonra antibiyotiklere karşı tamamen direnç kazanacak!
Yakın Doğu Üniversitesi akademisyenlerinin 35 yıllık projeksiyonu gösteren çalışmalarının sonuçlarına göre; kan, yara ve idrar yolu enfeksiyonları ile menenjit ve zatürre gibi hastalıklara neden olan “Klebsiella pneumoniae” bakterisinin dirençli türleri, 5 yıl sonra antibiyotiklere tamamen dirençli hale gelecek. Bu durum, bu bakterinin neden olduğu enfeksiyon hastalıklarında ölüm oranlarını artırabilir!
İnsan vücudunda pek çok enfeksiyon hastalığına neden olan bakterilerin olumsuz etkilerini ortadan kaldırmak ve enfeksiyonların yayılmalarını önlemek için antibiyotikler kritik bir öneme sahiptir. Ancak, uzun süredir antibiyotiklerin aşırı ve kontrolsüz kullanımı, tedavide kullanılan antibiyotiklerin belirli enfeksiyonlara karşı daha az etkili hale gelmelerine ve birçok farklı antibiyotiğe karşı dirençli bakterilerin ortaya çıkmasına neden oluyor. Bu durum, enfeksiyon hastalıklarının tedavisini ciddi bir mücadeleye dönüştürüyor. Diğer yandan bakterilerin, farklı antibiyotik gruplarına karşı geliştirdiği direnç, bakteri kaynaklı hastalıkların tedavilerini çıkmaza sürükleyebiliyor.
Yakın Doğu Üniversitesi DESAM Araştırma Enstitüsü araştırmacılarından Dr. Cemile Bağkur, Yakın Doğu Üniversitesi Matematik Araştırmaları Merkezi öğretim üyelerinden Doç. Dr. Bilgen Kaymakamzade ile yerel verilerden yararlanarak bakterilerdeki antibiyotik direncini ileriye dönük ortaya koyan 35 yıllık bir projeksiyon hazırladı.
Araştırmada, kan, yara ve idrar yolu enfeksiyonları ile menenjit ve zatürre gibi ciddi hastalıklara neden olan “Klebsiella pneumoniae” bakterisinin, genişletilmiş spektrumlu beta-laktamaz (GSBL) direnci adı verilen çoklu ilaç dirençli türlerinin iki ana antibiyotik grubuna karşı etkinliği analiz edilerek 35 yıllık bir projeksiyon ortaya konuldu. Araştırma, son çare olarak başvurulan karbapenem ve piperasilin-tazobaktam antibiyotik gruplarının, “Klebsiella pneumoniae” bakterisinin duyarlı türlerinde etkinliğini korurken, dirençli türlerin 5 yıl sonrasında bu antibiyotiklere karşı tamamen direnç kazanacağını ortaya koydu.
Farklı bakteri türlerinin antibiyotik dirençlerinin saptanmasında yol gösterici olacak çalışma, 40. Uluslararası Türk Mikrobiyoloji Kongresi’nde de sunularak Natural Sciences Publishing Yayınevine ait “Progress in Fractional Differentiation and Applications” dergisinde yayımlanmak üzere kabul edildi.

Dr. Cemile Bağkur: “Reçetesiz antibiyotik kullanımı daha etkili yasal düzenlemelerle sınırlandırılmalıdır.”
Araştırmada imzası bulunan Yakın Doğu Üniversitesi DESAM Araştırma Enstitüsü araştırmacılarından Dr. Cemile Bağkur, kullandıkları fraksiyonel modelin ileri yıllardaki farklı bakteri türlerinin antibiyotik direncinin belirlenmesinde önemli bir araç olarak uygulanabileceğini ve tedbirlerin alınmasında yol gösterici olacağını ifade ederek, “Klebsiella pneumoniae” bakterisi üzerinde yaptığımız araştırmalar, bu bakterinin dirençli türlerinin 5 yıl sonra, son çare olarak başvurulan antibiyotiklere karşı tamamen direnç kazanabileceğini ortaya koydu. Bu durum, bu bakterinin neden olduğu enfeksiyon hastalıklarında tedaviyi güçleştirerek ağır enfeksiyonların ve ilişkili ölümlerin oranında artışa neden olabilir” değerlendirmesini yaptı. Yeni antibiyotik gruplarının geliştirilmesinin zaman aldığını hatırlatan Dr. Bağkur, bu bakterilerin zaman içerisinde yeni geliştirilen antibiyotik gruplarına da direnç kazanabileceği uyarısında bulundu.
Akılcı antibiyotik kullanımının daha fazla benimsenmesi gerektiğini vurgulayan Dr. Cemile Bağkur, “Doğru antibiyotik kullanımı için, mikrobiyolojik olarak kanıtlanmış bakteriyel bir enfeksiyonun varlığı mutlaka sorgulanmalıdır. Kesinleşmeyen durumlarda ise antibiyotik kullanımından kaçınılmalıdır” ifadesini kullandı. Reçetesiz antibiyotik kullanımının önüne geçilmesi gerektiğinin altını çizen Dr. Bağkur, “Halkı, antibiyotik kullanımı ile ilgili olarak kamu spotları ve doktorların çabaları ile bilinçlendirmeliyiz” dedi.

-001.gif)










































Türkçe karakter kullanılmayan ve büyük harflerle yazılmış yorumlar onaylanmamaktadır.